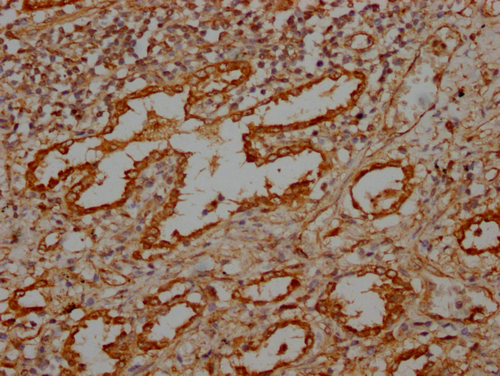

MBTPS1 Antibody
-
中文名稱:MBTPS1兔多克隆抗體
-
貨號:CSB-PA617930LA01HU
-
規(guī)格:¥440
-
圖片:
-
IHC image of CSB-PA617930LA01HU diluted at 1:100 and staining in paraffin-embedded human lung tissue performed on a Leica BondTM system. After dewaxing and hydration, antigen retrieval was mediated by high pressure in a citrate buffer (pH 6.0). Section was blocked with 10% normal goat serum 30min at RT. Then primary antibody (1% BSA) was incubated at 4°C overnight. The primary is detected by a Goat anti-rabbit IgG labeled by HRP and visualized using 0.05% DAB.
-
-
其他:
產(chǎn)品詳情
-
產(chǎn)品名稱:Rabbit anti-Homo sapiens (Human) MBTPS1 Polyclonal antibody
-
Uniprot No.:
-
基因名:
-
別名:Membrane-bound transcription factor site-1 protease (EC 3.4.21.112) (Endopeptidase S1P) (Subtilisin/kexin-isozyme 1) (SKI-1), MBTPS1, KIAA0091 S1P SKI1
-
宿主:Rabbit
-
反應種屬:Human
-
免疫原:Recombinant Human Membrane-bound transcription factor site-1 protease protein (187-400aa)
-
免疫原種屬:Homo sapiens (Human)
-
標記方式:Non-conjugated
本頁面中的產(chǎn)品,MBTPS1 Antibody (CSB-PA617930LA01HU),的標記方式是Non-conjugated。對于MBTPS1 Antibody,我們還提供其他標記。見下表:
-
克隆類型:Polyclonal
-
抗體亞型:IgG
-
純化方式:>95%, Protein G purified
-
濃度:It differs from different batches. Please contact us to confirm it.
-
保存緩沖液:Liquid in PBS containing 50% glycerol, 0.5% BSA and 0.02% sodium azide.
-
產(chǎn)品提供形式:Liquid
-
應用范圍:ELISA, IHC
-
推薦稀釋比:
Application Recommended Dilution IHC 1:100-1:500 -
Protocols:
-
儲存條件:Upon receipt, store at -20°C or -80°C. Avoid repeated freeze.
-
貨期:Basically, we can dispatch the products out in 1-3 working days after receiving your orders. Delivery time maybe differs from different purchasing way or location, please kindly consult your local distributors for specific delivery time.
-
用途:For Research Use Only. Not for use in diagnostic or therapeutic procedures.
相關(guān)產(chǎn)品
靶點詳情
-
功能:Serine protease that cleaves after hydrophobic or small residues, provided that Arg or Lys is in position P4: known substrates are SREBF1/SREBP1, SREBF2/SREBP2, BDNF, GNPTAB, ATF6 and ATF6B. Cleaves substrates after Arg-Ser-Val-Leu (SREBP2), Arg-His-Leu-Leu (ATF6), Arg-Gly-Leu-Thr (BDNF) and its own propeptide after Arg-Arg-Leu-Leu. Catalyzes the first step in the proteolytic activation of the sterol regulatory element-binding proteins (SREBPs) SREBF1/SREBP1 and SREBF2/SREBP2. Also mediates the first step in the proteolytic activation of the cyclic AMP-dependent transcription factor ATF-6 (ATF6 and ATF6B). Mediates the protein cleavage of GNPTAB into subunit alpha and beta, thereby participating in biogenesis of lysosomes. Involved in the regulation of M6P-dependent Golgi-to-lysosome trafficking of lysosomal enzymes. It is required for the activation of CREB3L2/BBF2H7, a transcriptional activator of MIA3/TANGO and other genes controlling mega vesicle formation. Therefore, it plays a key role in the regulation of mega vesicle-mediated collagen trafficking.
-
基因功能參考文獻:
- rs11642644 associated with facial profile PMID: 29301965
- In the absence of S1P, the catalytically inactive alpha/beta-subunit precursor of GlcNAc-1-phosphotransferase fails to be activated and results in missorting of newly synthesized lysosomal enzymes, and lysosomal accumulation of non-degraded material, which are biochemical features of defective GlcNAc-1-phosphotransferase subunits and the associated pediatric lysosomal diseases mucolipidosis type II and III. PMID: 28693924
- Results suggest that (pro)renin receptor (s(P)RR) is generated by sequential processing by site-1 protease (S1P) and furin protein. PMID: 28013223
- primordial SKI-1/S1P likely contained a simpler prodomain consisting of the highly conserved AB fragment that represents an independent folding unit PMID: 26645686
- S1P substrate-dependent regulatory mechanisms for lipid synthesis and biogenesis of lysosomes are different PMID: 26108224
- The interaction between S1P and C5a plays an important role in neutrophils for antineutrophil cytoplasmic antibody -mediated activation PMID: 25000985
- Incompletely matured forms of SKI-1/S1P further process cellular and viral substrates in distinct subcellular compartments. PMID: 25378398
- We show that SKI-1 is constitutively expressed in human pigment cells with higher SKI activity in seven out of eight melanoma cell lines compared with normal melanocytes. PMID: 23884247
- Diabetic high-density lipoprotein carries higher levels of S1P compared with normal high-density lipoprotein. PMID: 23360427
- Y285 of SKI-1 is crucial for the efficient processing of envelope glycoproteins from Old World and clade C New World arenavirus. PMID: 23536681
- The role of MBTPS1 (SKI-1/S1P) peptides in cancer and approaches used to inhibit SKI-1/S1P were studied. PMID: 21568902
- study found that the N-acetylglucosamine-1-phosphotransferase alpha/beta-subunit precursor is cleaved by S1P that activates sterol regulatory element-binding proteins in response to cholesterol deprivation; S1P functions in the biogenesis of lysosomes PMID: 21719679
- S1P has a role in reducing the size of the luminal domain to prepare ATF6 to be an optimal S2P substrate PMID: 15299016
- enzymatic activity of S1P is not calcium dependent, but can be modulated by a variety of mono- and divalent cations. S1P displayed pronounced positive cooperativity with a substrate derived from the viral coat glycoprotein of the lassa virus. PMID: 16973377
- SKI-1/S1P inhibition resulted in reduced cholesterol synthesis and mRNA levels of the rate-limiting enzymes, HMG-CoA reductase and squalene epoxidase, in the cholesterol synthetic pathway. PMID: 17867930
- Complementation of SKI-1/S1P-deficient cells with a SKI-1/S1P expression vector restored release of infectious Crimean-Congo hemorrhagic fever virus (>106 PFU/ml), confirming that SKI-1/S1P processing is required for incorporation of viral glycoproteins. PMID: 17898072
- Site 1 protease is required for proteolytic processing of the glycoproteins of the South American hemorrhagic fever viruses Junin, Machupo, and Guanarito. PMID: 18400865
顯示更多
收起更多
-
亞細胞定位:Endoplasmic reticulum membrane; Single-pass type I membrane protein. Golgi apparatus membrane; Single-pass type I membrane protein.
-
蛋白家族:Peptidase S8 family
-
組織特異性:Widely expressed.
-
數(shù)據(jù)庫鏈接:
Most popular with customers
-
-
Phospho-YAP1 (S127) Recombinant Monoclonal Antibody
Applications: ELISA, WB, IHC
Species Reactivity: Human
-
-
-
-
-
-